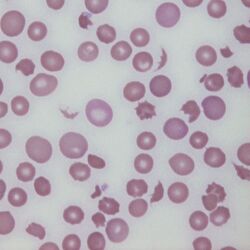

Keratocytes
From haematologyetc.co.uk
(horned cells, bite cells, helmet cells)
Derivation: Latin Kerat (horn)
Appearance
Keratocytes usually have a single pair of spicules (hence the name horned cells); these generally frame a concave area of cell membrane, this gives rise to the alternative name of bite cell. Sometimes more than two "horns" are present and a gradual progression to fragments may be seen.
Images: Note the two typical horns surrounding a central depression in the drawn image - the origin as a vacuole that has ruptured (see Pathogenesis) is easy to imagine. The cartoon image shows one typical keratocyte (arrowed), but also emphasises the more widespread damage that ofetn accompany these forms with other damaged cells and precursor red cells present.
Significance
The presence of keratocytes always implies the mechanical destruction of erythrocytes and is therefore highly significant and often requires urgent reporting. In some (although not all) cases, the pathological process may be life threatening particularly if they are associated with disseminated intravascular coagulation (DIC) or thrombotic thrombocytopenic purpura (TTP) knowledge of platelet count, clotting and additional morphological features such as fragments is essential.
Pitfalls
The keratocyte istself is quite distinctive, however be aware of the range of causes that are not limited to microvascular damage. The appearance may also be a sign of ocidative damage or Heinz body removal. Careful attention to other features is important.
| Microvascular damage |
|---|
| Disseminated intravascular coagulation (DIC), Thrombotic thrombocytopenic purpura (TTP), Renal disease particularly vasculitis, Disseminated malignancy |
| Physical trauma |
| Particularly defective prosthetic heart valve or valve disease with turbulent flow |
| Red cell fragility |
| e.g. iron deficiency, thalassaemia, megaloblastic anaemia, MDS (look for associated features) |
| Removal of denatured haemoglobin |
| oxidant damage (see also blister cells) Alpha thalassaemia |
| Less commonly |
| Small numbers may occur in liver disease and splenectomy |
Clinical Examples
Clinical Image 1: Typical keratocyte forms, most have two horns surrounding a central depression. There are also some echinocytes present. Clinical diagnosis: Oxidative damage and Heinz body removal
Clinical Image 2: Further typical keratocyte forms, note a cell with three horns (*) surrounding two central depressions. Here there is more extensive evidence of additional erythrocyte damage – (echinocytes, spherocytes and early fragments) and absent platelets. Clinical diagnosis: Thrombotic thrombocytopenic purpura
Clinical Image 3: In this case damage is considerable, and typical keratocytes are no longer present – being replaced by fragmented cells, however same pathological origin can still be detected with residual bites and horns. Note also the polychromatic cells formed by the marrow response to cell destruction. Clinical diagnosis: Thrombotic thrombocytopenic purpura
Pathobiology
The horn-like paired projections are caused by trauma to the cell; this is most commonly caused by slicing of the cell by fibrin strands within the microvasculature. The damage is followed by repair through spontaneous membrane fusion forming a pseudovacuole; this fragile structure rapidly ruptures giving rise to the characteristic appearance of a concave defect, with surrounding horns that are the residual walls of the vacuole. Pitfalls The appearance of the keratocyte is characteristic. However, there are two potential sources of confusion: first when multiple horns are present on the cell, where they need to be distinguished from echinocytes or acanthocytes: look for the characteristic depression between the horns. When damage is more severe the keratocytes become increasingly irregular, form small sharp-edged fragments which can usually be detected. Occasionally, the cells may also be confused with the blister cells or hemighosts formed in response to oxidative damage the key is whether there is a retained membrane wall (a blister) or no wall (a bite).